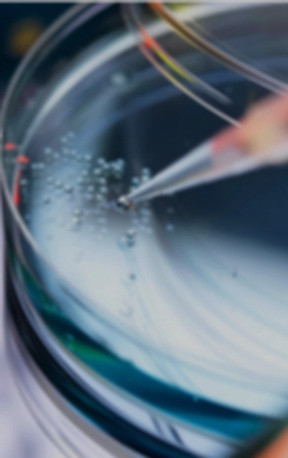
Biocompability and Toxicology Studies_ed

top of page
Discover how safety checks after sterilization ensure safety for products before it's released
Explore how our experts prove your sterilization method effectiveness
Discover services that ensures your products are free from viable microorganisms
Our Customers


bottom of page

.png)